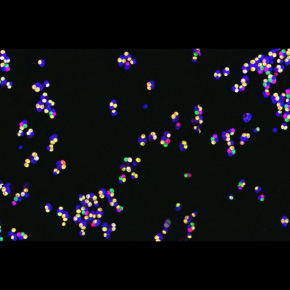

Méiose et crossing overs : s’apparier pour mieux se séparer
Au sein de la lignée germinale, la méiose, au sein des cellules progénitrices diploides (2n chromosomes) sépare les chromosomes « homologues » (d'origine maternelle ou paternelle) pour former les gamète (n chromosomes). Cela repose sur un processus très sophistiqué, présent de la levure à l’humain, où les chromosomes homologues s’apparient entre eux sur toute leur longueur grâce au complexe synaptonémal. Ils y échangent des régions d’ADN, ce qui les « lie » temporairement, et permet le brassage génétique, la recombinaison. En utilisant le modèle de la levure Saccharomyces cerevisiae, les scientifiques ont identifié les bases moléculaires de ce mécanisme qui unit appariement et recombinaison. Ce travail est publié dans la revue Genes and Development.
Laboratoire de la circonscription Paris-Centre impliqué dans cette étude :
- Dynamique de l'information génétique : bases fondamentales et cancer (DIG-Cancer, CNRS/Institut Curie/Sorbonne Université)